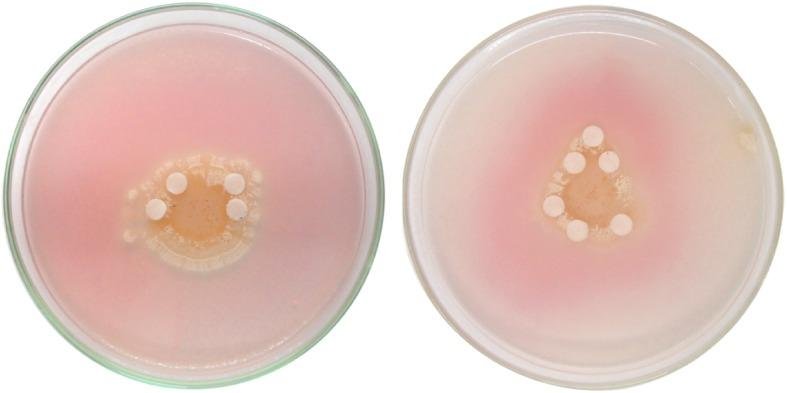
https://cdn.ncbi.nlm.nih.gov/pmc/blobs/edc3/7149892/2c70fbf22316/12866_2020_1775_Fig1_HTML.jpg

鉴定胆固醇同化放线菌菌株和应用统计建模方法提高链霉菌属 NEAE-94 菌株产胆固醇氧化酶的研究。
Identification of cholesterol-assimilating actinomycetes strain and application of statistical modeling approaches for improvement of cholesterol oxidase production by Streptomyces anulatus strain NEAE-94.
机构信息
Department of Bioprocess Development, Genetic Engineering and Biotechnology Research Institute, City for Scientific Research and Technological Applications, (SRTA-City), Alexandria, Egypt.
出版信息
BMC Microbiol. 2020 Apr 10;20(1):86. doi: 10.1186/s12866-020-01775-x.
BACKGROUND
Cholesterol oxidase biosensors have been used to determine the level of cholesterol in different serum and food samples. Due to a wide range of industrial and clinical applications of microbial cholesterol oxidase, isolation and identification of a new microbial source (s) of cholesterol oxidase are very important.
RESULTS
The local isolate Streptomyces sp. strain NEAE-94 is a promising source of cholesterol oxidase. It was identified based on cultural, morphological and physiological characteristics; in addition to the 16S rRNA sequence. The sequencing product had been deposited in the GenBank database under the accession number KC354803. Cholesterol oxidase production by Streptomyces anulatus strain NEAE-94 in shake flasks was optimized using surface response methodology. The different process parameters were first screened using a Plackett-Burman design and the parameters with significant effects on the production of cholesterol oxidase were identified. Out of the 15 factors screened, agitation speed, cholesterol and yeast extract concentrations had the most significant positive effects on the production of cholesterol oxidase. The optimal levels of these variables and the effects of their mutual interactions on cholesterol oxidase production were determined using Box-Behnken design. Cholesterol oxidase production by Streptomyces anulatus strain NEAE-94 was 11.03, 27.31 U/mL after Plackett-Burman Design and Box-Behnken design; respectively, with a fold of increase of 6.06 times compared to the production before applying the Plackett-Burman design (4.51 U/mL).
CONCLUSIONS
Maximum cholesterol oxidase activity was obtained at the following fermentation conditions: g/L (cholesterol 4, yeast extract 5, NaCl 0.5, KHPO 1, FeSO.7HO 0.01, MgSO.7HO 0.5), pH 7, inoculum size 4% (v/v), temperature 37°C, agitation speed of 150 rpm, medium volume 50 mL and incubation time 5 days.
背景
胆固醇氧化酶生物传感器已被用于测定不同血清和食物样本中的胆固醇水平。由于微生物胆固醇氧化酶具有广泛的工业和临床应用,因此分离和鉴定新的微生物胆固醇氧化酶来源非常重要。
结果
当地分离的链霉菌属菌株 NEAE-94 是胆固醇氧化酶的一个很有前途的来源。它是基于文化、形态和生理特征确定的;此外还有 16S rRNA 序列。测序产物已在 GenBank 数据库中注册,登录号为 KC354803。使用表面响应法优化了链霉菌属菌株 NEAE-94 在摇瓶中的胆固醇氧化酶生产。首先使用 Plackett-Burman 设计筛选不同的工艺参数,并确定对胆固醇氧化酶生产有显著影响的参数。在所筛选的 15 个因素中,搅拌速度、胆固醇和酵母提取物浓度对胆固醇氧化酶的生产有最显著的积极影响。使用 Box-Behnken 设计确定这些变量的最佳水平及其相互作用对胆固醇氧化酶生产的影响。经过 Plackett-Burman 设计和 Box-Behnken 设计后,链霉菌属菌株 NEAE-94 的胆固醇氧化酶产量分别为 11.03 和 27.31 U/mL,与应用 Plackett-Burman 设计前的产量(4.51 U/mL)相比,增加了 6.06 倍。
结论
在以下发酵条件下可获得最大胆固醇氧化酶活性:g/L(胆固醇 4、酵母提取物 5、NaCl 0.5、KHPO 1、FeSO.7HO 0.01、MgSO.7HO 0.5)、pH 7、接种量 4%(v/v)、温度 37°C、搅拌速度 150 rpm、培养基体积 50 mL 和培养时间 5 天。